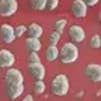

Similar products
Similar products

Wholesale Stainless steel flower earrings
Wholesale Stainless steel flower earrings
Wholesale Stainless steel flower earrings
Wholesale Stainless steel flower earrings
WSP
ā¬15.90 MSRP
Shipping & policies
- Estimated delivery Nov 17-27
Free and easy returns. Learn more
With Faire, shop unique wholesale products for your store from brands like LOLO & YAYA and more.
Description
Stainless steel earrings, water-resistant
This info has been automatically translated.
Details
SKU: 44090-2 Made in China Weight: 20 g (0.71 oz)